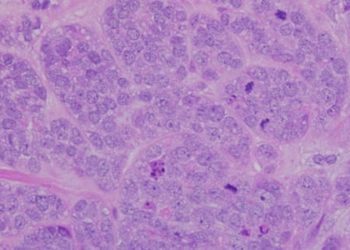
25% reoperation risk after breast-conserving lumpectomy

Preoperative breast MRI may reduce need for adjuvant radiotherapy for women with unifocal breast cancer
1. There were similar rates of ipsilateral invasive recurrence among the postoperative adjuvant radiotherapy group (group 1) and non-radiotherapy group ...